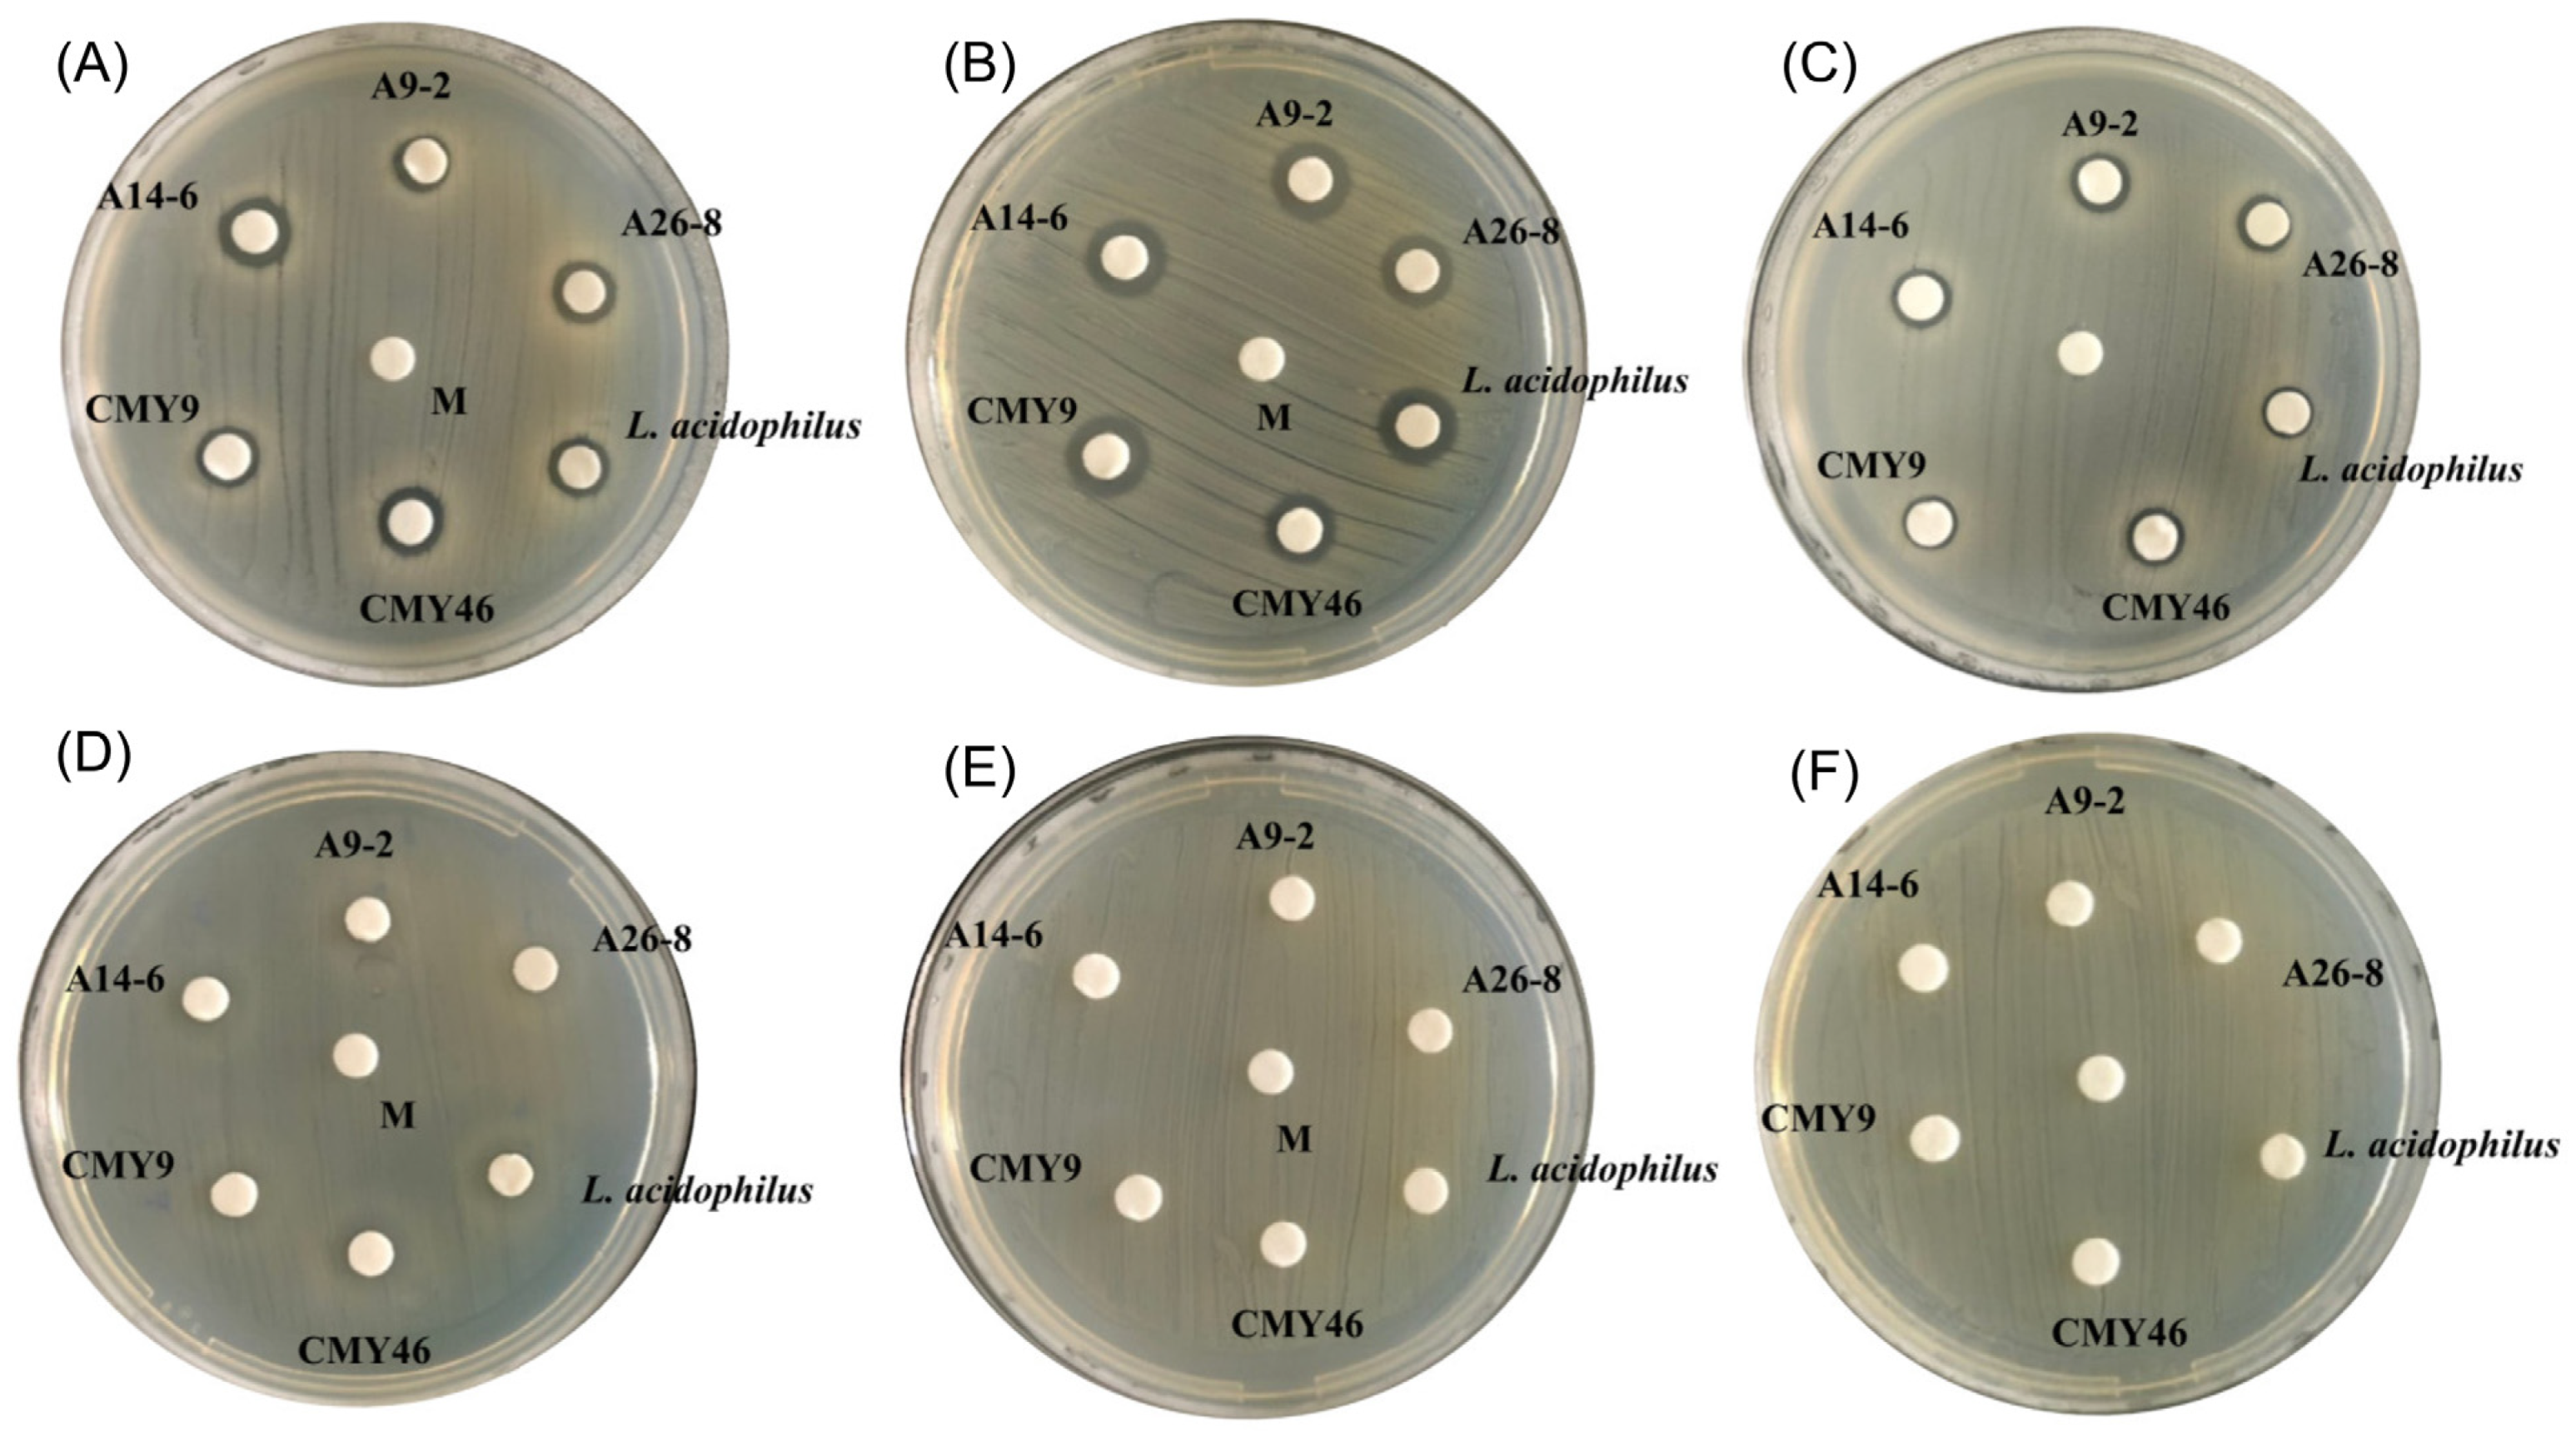
Fermentation 07 00195 g002 550

Probiotic and Antioxidant Properties of Lactic Acid Bacteria Isolated from Indigenous Fermented Tea Leaves (Miang) of North Thailand and Promising Application in Synbiotic Formulation
Abstract
:1. Introduction
2. Materials and Methods
2.1. Bacterial Strains and Culture Conditions
2.2. Screening and Selection of Acid and Bile Salt Tolerant LAB as the Potent Probiotic
2.3. Identification and Characterization of Lactic Acid Bacteria
2.4. Antimicrobial Activity against Pathogens
2.5. Resistance to Simulated Gastrointestinal Conditions
2.6. Auto-Aggregation
2.7. Cell Surface Hydrophobicity
2.8. Antibiotic Resistance
2.9. Hemolytic Activity Test
2.10. DPPH Free Radical Scavenging Ability
2.11. Prebiotic Utilization
2.12. Viability of Probiotic Strains after Spray-Drying
2.13. Statistical Analysis
3. Results and Discussion
3.1. Screening and Selection of Acid and Bile Salt Tolerance LAB as Potential Probiotic
3.2. Identification of LAB
3.3. Antimicrobial Activity against Pathogens
3.4. Survival in the Simulated Gastrointestinal Conditions
3.5. Resistance to Antibiotics
3.6. Hydrophobicity and Auto-Aggregation
3.7. Radical Scavenging Activities of LAB
3.8. Prebiotic Utilization and Prebiotic Scores
3.9. Viability of Probiotic Strains during Spray-Drying
4. Conclusions
Author Contributions
Funding
Institutional Review Board Statement
Informed Consent Statement
Data Availability Statement
Acknowledgments
Conflicts of Interest
References
- Hill, C.; Guarner, F.; Reid, G.; Gibson, G.R.; Merenstein, D.J.; Pot, B.; Morelli, L.; Canani, R.B.; Flint, H.J.; Salminen, S. Expert consensus document: The International Scientific Association for Probiotics and Prebiotics consensus statement on the scope and appropriate use of the term probiotic. Nat. Rev. Gastroenterol. Hepatol. 2014, 11, 506. [Google Scholar] [CrossRef] [Green Version]
- Lee, K.W.; Shim, J.M.; Park, S.-K.; Heo, H.-J.; Kim, H.-J.; Ham, K.-S.; Kim, J.H. Isolation of lactic acid bacteria with probiotic potentials from kimchi, traditional Korean fermented vegetable. LWT-Food Sci. Technol. 2016, 71, 130–137. [Google Scholar] [CrossRef]
- Vinderola, G.; Cespedes, M.; Mateolli, D.; Cardenas, P.; Lescano, M.; Aimaretti, N.; Reinheimer, J. Changes in gastric resistance of Lactobacillus casei in flavoured commercial fermented milks during refrigerated storage. Int. J. Dairy Technol. 2011, 64, 269–275. [Google Scholar] [CrossRef]
- Byakika, S.; Mukisa, I.M.; Byaruhanga, Y.B.; Muyanja, C. A review of criteria and methods for evaluating the probiotic potential of microorganisms. Food Rev. Int. 2019, 35, 427–466. [Google Scholar] [CrossRef]
- Rubio, R.; Jofré, A.; Martín, B.; Aymerich, T.; Garriga, M. Characterization of lactic acid bacteria isolated from infant faeces as potential probiotic starter cultures for fermented sausages. Food Microbiol. 2014, 38, 303–311. [Google Scholar] [CrossRef]
- Forssten, S.D.; Sindelar, C.W.; Ouwehand, A.C. Probiotics from an industrial perspective. Anaerobe 2011, 17, 410–413. [Google Scholar] [CrossRef]
- Tripathi, M.K.; Giri, S.K. Probiotic functional foods: Survival of probiotics during processing and storage. J. Funct. Foods 2014, 9, 225–241. [Google Scholar] [CrossRef]
- Reque, P.M.; Brandelli, A. Encapsulation of probiotics and nutraceuticals: Applications in functional food industry. Trends Food Sci. Technol. 2021, 114, 1–10. [Google Scholar] [CrossRef]
- Sartor, R.B. Therapeutic manipulation of the enteric microflora in inflammatory bowel diseases: Antibiotics, probiotics, and prebiotics. Gastroenterology 2004, 126, 1620–1633. [Google Scholar] [CrossRef] [PubMed] [Green Version]
- Vallianou, N.; Stratigou, T.; Christodoulatos, G.S.; Tsigalou, C.; Dalamaga, M. Probiotics, prebiotics, synbiotics, postbiotics, and obesity: Current evidence, controversies, and perspectives. Curr. Obes. Rep. 2020, 9, 1–14. [Google Scholar] [CrossRef] [PubMed]
- Pandey, K.R.; Naik, S.R.; Vakil, B.V. Probiotics, prebiotics and synbiotics—A review. J. Food Sci. Technol. 2015, 52, 7577–7587. [Google Scholar] [CrossRef] [PubMed]
- Patel, A.; Prajapati, J.; Holst, O.; Ljungh, A. Determining probiotic potential of exopolysaccharide producing lactic acid bacteria isolated from vegetables and traditional Indian fermented food products. Food Biosci. 2014, 5, 27–33. [Google Scholar] [CrossRef]
- Khanongnuch, C.; Unban, K.; Kanpiengjai, A.; Saenjum, C. Recent research advances and ethno-botanical history of miang, a traditional fermented tea (Camellia sinensis var. assamica) of Northern Thailand. J. Ethn. Foods 2017, 4, 135–144. [Google Scholar] [CrossRef]
- Kanpiengjai, A.; Chui-Chai, N.; Chaikaew, S.; Khanongnuch, C. Distribution of tannin-tolerant yeasts isolated from Miang, a traditional fermented tea leaf (Camellia sinensis var. assamica) in northern Thailand. Int. J. Food Microbiol. 2016, 238, 121–131. [Google Scholar] [CrossRef]
- Unban, K.; Khatthongngam, N.; Shetty, K.; Khanongnuch, C. Nutritional biotransformation in traditional fermented tea (Miang) from north Thailand and its impact on antioxidant and antimicrobial activities. J. Food Sci. Technol. 2019, 56, 2687–2699. [Google Scholar] [CrossRef] [PubMed]
- Chaikaew, S.; Baipong, S.; Sone, T.; Kanpiengjai, A.; Chui-chai, N.; Asano, K.; Khanongnuch, C. Diversity of lactic acid bacteria from Miang, a traditional fermented tea leaf in northern Thailand and their tannin-tolerant ability in tea extract. J. Microbiol. 2017, 55, 720–729. [Google Scholar] [CrossRef]
- Gharaei-Fathabad, E.; Eslamifar, M. Isolation and applications of one strain of Lactobacillus paraplantarum from tea leaves (Camellia sinensis). Am. J. Food Technol. 2011, 6, 429–434. [Google Scholar] [CrossRef]
- Okada, S.; Takahashi, N.; Ohara, N.; Uchimura, T.; Kozaki, M. Microorganisms involving in the fermentation of Japanese fermented tea leaves, 2: Microorganisms in fermentation of Goishi-cha, Japanese fermented tea leaves. J. Jpn. Soc. Food. Sci. Technol. 1996, 43, 1019–1027. [Google Scholar] [CrossRef] [Green Version]
- Sukontasing, S.; Tanasupawat, S.; Moonmangmee, S.; Lee, J.S.; Suzuki, K.I. Enterococcus camelliae sp. nov., isolated from fermented tea leaves in Thailand. Int. J. Syst. Evol. Microbiol. 2007, 57, 2151–2154. [Google Scholar] [CrossRef] [Green Version]
- Tanasupawat, S.; Pakdeeto, A.; Thawai, C.; Yukphan, P.; Okada, S. Identification of lactic acid bacteria from fermented tea leaves (miang) in Thailand and proposals of Lactobacillus thailandensis sp. nov., Lactobacillus camelliae sp. nov., and Pediococcus siamensis sp. nov. J. Gen. Appl. Microbiol. 2007, 53, 7–15. [Google Scholar] [CrossRef] [Green Version]
- Unban, K.; Khatthongngam, N.; Pattananandecha, T.; Saenjum, C.; Shetty, K.; Khanongnuch, C. Microbial community dynamics during the non-filamentous fungi growth-based fermentation process of Miang, a traditional fermented tea of north Thailand and their product characterizations. Front. Microbiol. 2020, 11, 1–15. [Google Scholar] [CrossRef] [PubMed]
- Kodchasee, P.; Nain, K.; Abdullahi, A.D.; Unban, K.; Saenjum, C.; Shetty, K.; Khanongnuch, C. Microbial dynamics-linked properties and functional metabolites during Miang fermentation using the filamentous fungi growth-based process. Food Biosci. 2021, 41, 100998. [Google Scholar] [CrossRef]
- Argyri, A.A.; Zoumpopoulou, G.; Karatzas, K.A.G.; Tsakalidou, E.; Nychas, G.J.E.; Panagou, E.Z.; Tassou, C.C. Selection of potential probiotic lactic acid bacteria from fermented olives by in vitro tests. Food Microbiol. 2013, 33, 282–291. [Google Scholar] [CrossRef] [PubMed]
- García-Hernández, Y.; Pérez-Sánchez, T.; Boucourt, R.; Balcázar, J.L.; Nicoli, J.R.; Moreira-Silva, J.; Rodríguez, Z.; Fuertes, H.; Nuñez, O.; Albelo, N. Isolation, characterization and evaluation of probiotic lactic acid bacteria for potential use in animal production. Res. Vet. Sci. 2016, 108, 125–132. [Google Scholar] [CrossRef]
- Tamura, K.; Dudley, J.; Nei, M.; Kumar, S. MEGA4: Molecular evolutionary genetics analysis (MEGA) software version 4.0. Mol. Biol. Evol. 2007, 24, 1596–1599. [Google Scholar] [CrossRef]
- Torriani, S.; Felis, G.E.; Dellaglio, F. Differentiation of Lactobacillus plantarum, L. pentosus, and L. paraplantarum by recA gene sequence analysis and multiplex PCR assay with recA gene-derived primers. Appl. Environ. Microbiol. 2001, 67, 3450–3454. [Google Scholar] [CrossRef] [Green Version]
- Sriphannam, W.; Lumyong, S.; Niumsap, P.; Ashida, H.; Yamamoto, K.; Khanongnuch, C. A selected probiotic strain of Lactobacillus fermentum CM33 isolated from breast-fed infants as a potential source of β-galactosidase for prebiotic oligosaccharide synthesis. J. Microbiol. 2012, 50, 119–126. [Google Scholar] [CrossRef]
- Xu, H.; Jeong, H.; Lee, H.; Ahn, J. Assessment of cell surface properties and adhesion potential of selected probiotic strains. Lett. Appl. Microbiol. 2009, 49, 434–442. [Google Scholar] [CrossRef] [PubMed]
- Charteris, W.P.; Kelly, P.M.; Morelli, L.; Collins, J.K. Antibiotic susceptibility of potentially probiotic Lactobacillus species. J. Food Prot. 1998, 61, 1636–1643. [Google Scholar] [CrossRef]
- CLSI. Performance Standards for Antimicrobial Susceptibility Testing; Twenty-Fifth Informational Supplement; Clinical and Laboratory Standards Institute: Wayne, PA, USA, 2012. [Google Scholar]
- Angmo, K.; Kumari, A.; Bhalla, T.C. Probiotic characterization of lactic acid bacteria isolated from fermented foods and beverage of Ladakh. LWT-Food Sci. Technol. 2016, 66, 428–435. [Google Scholar] [CrossRef]
- Cao, Z.; Pan, H.; Li, S.; Shi, C.; Wang, S.; Wang, F.; Ye, P.; Jia, J.; Ge, C.; Lin, Q. In vitro evaluation of probiotic potential of lactic acid Bacteria isolated from Yunnan De’ang pickled tea. Probiotics Antimicrob. Proteins 2019, 11, 103–112. [Google Scholar] [CrossRef] [PubMed]
- Kondepudi, K.K.; Ambalam, P.; Nilsson, I.; Wadstr, T. Prebiotic-non-digestible oligosaccharides preference of probiotic bifidobacteria and antimicrobial activity against Clostridium difficile. Anaerobe 2012, 18, 489–497. [Google Scholar] [CrossRef]
- Zhu, Z.; Luan, C.; Zhang, H.; Zhang, L.; Hao, Y. Effects of spray drying on Lactobacillus plantarum BM-1 viability, resistance to simulated gastrointestinal digestion, and storage stability. Dry. Technol. 2016, 34, 177–184. [Google Scholar] [CrossRef]
- Quinto, E.J.; Jiménez, P.; Caro, I.; Tejero, J.; Mateo, J.; Girbés, T. Probiotic lactic acid bacteria: A review. Food Nutr. Sci. 2014, 5, 1765. [Google Scholar] [CrossRef] [Green Version]
- Papadimitriou, K.; Zoumpopoulou, G.; Foligné, B.; Alexandraki, V.; Kazou, M.; Pot, B.; Tsakalidou, E. Discovering probiotic microorganisms: In vitro, in vivo, genetic and omics approaches. Front. Microbiol. 2015, 6, 58. [Google Scholar] [CrossRef] [PubMed] [Green Version]
- Mathara, J.M.; Schillinger, U.; Kutima, P.M.; Mbugua, S.K.; Guigas, C.; Franz, C.; Holzapfel, W.H. Functional properties of Lactobacillus plantarum strains isolated from Maasai traditional fermented milk products in Kenya. Curr. Microbiol. 2008, 56, 315–321. [Google Scholar] [CrossRef] [PubMed]
- Solieri, L.; Bianchi, A.; Mottolese, G.; Lemmetti, F.; Giudici, P. Tailoring the probiotic potential of non-starter Lactobacillus strains from ripened Parmigiano Reggiano cheese by in vitro screening and principal component analysis. Food Microbiol. 2014, 38, 240–249. [Google Scholar] [CrossRef]
- Goldin, B.; Gorbach, S. Probiotics for humans. In Probiotics, the Scientific Basis; Fuller, R., Ed.; Chapman and Hall: London, UK, 1992; pp. 355–376. [Google Scholar]
- Jose, N.M.; Bunt, C.R.; Hussain, M.A. Comparison of microbiological and probiotic characteristics of lactobacilli isolates from dairy food products and animal rumen contents. Microorganisms 2015, 3, 198–212. [Google Scholar] [CrossRef] [Green Version]
- Klayraung, S.; Viernstein, H.; Sirithunyalug, J.; Okonogi, S. Probiotic properties of Lactobacilli isolated from Thai traditional food. Sci. Pharm. 2008, 76, 485–504. [Google Scholar] [CrossRef] [Green Version]
- Tanasupawat, S.; Ezaki, T.; Suzuki, K.I.; Okada, S.; Komagata, K.; Kozaki, M. Characterization and identification of Lactobacillus pentosus and Lactobacillus plantarum strains from fermented foods in Thailand. J. Gen. Appl. Microbiol. 1992, 38, 121–134. [Google Scholar] [CrossRef] [Green Version]
- Gao, Z.; Daliri, E.B.-M.; Wang, J.; Liu, D.; Chen, S.; Ye, X.; Ding, T. Inhibitory effect of lactic acid bacteria on foodborne pathogens: A review. J. Food Prot. 2019, 82, 441–453. [Google Scholar] [CrossRef]
- Sankar, N.R.; Priyanka, V.D.; Reddy, P.S.; Rajanikanth, P.; Kumar, V.K.; Indira, M. Purification and characterization of bacteriocin produced by Lactobacillus plantarum isolated from cow milk. Int. J. Microbiol. Res. 2012, 3, 133–137. [Google Scholar]
- Kechagia, M.; Basoulis, D.; Konstantopoulou, S.; Dimitriadi, D.; Gyftopoulou, K.; Skarmoutsou, N.; Fakiri, E.M. Health benefits of probiotics: A review. ISRN Nutr. 2013, 2013, 481651. [Google Scholar] [CrossRef] [Green Version]
- Unban, K.; Kodchasee, P.; Shetty, K.; Khanongnuch, C. Tannin-tolerant and extracellular tannase producing Bacillus isolated from traditional fermented tea leaves and their probiotic functional properties. Foods 2020, 9, 490. [Google Scholar] [CrossRef] [PubMed]
- Mathur, S.; Singh, R. Antibiotic resistance in food lactic acid bacteria-a review. Int. J. Food Microbiol. 2005, 105, 281–295. [Google Scholar] [CrossRef] [PubMed]
- Salminen, S.; von Wright, A.; Morelli, L.; Marteau, P.; Brassart, D.; de Vos, W.M.; Fondén, R.; Saxelin, M.; Collins, K.; Mogensen, G. Demonstration of safety of probiotics-a review. Int. J. Food Microbiol. 1998, 44, 93–106. [Google Scholar] [CrossRef]
- Manini, F.; Casiraghi, M.; Poutanen, K.; Brasca, M.; Erba, D.; Plumed-Ferrer, C. Characterization of lactic acid bacteria isolated from wheat bran sourdough. LWT-Food Sci. Technol. 2016, 66, 275–283. [Google Scholar] [CrossRef]
- Borriello, S.; Hammes, W.; Holzapfel, W.; Marteau, P.; Schrezenmeir, J.; Vaara, M.; Valtonen, V. Safety of probiotics that contain lactobacilli or bifidobacteria. Clin. Infect. Dis. 2003, 36, 775–780. [Google Scholar] [CrossRef]
- Menezes, A.G.T.; Ramos, C.L.; Cenzi, G.; Melo, D.S.; Dias, D.R.; Schwan, R.F. Probiotic potential, antioxidant activity, and phytase production of indigenous yeasts isolated from indigenous fermented foods. Probiotics Antimicrob. Proteins 2020, 12, 280–288. [Google Scholar] [CrossRef]
- Del Re, B.; Sgorbati, B.; Miglioli, M.; Palenzona, D. Adhesion, autoaggregation and hydrophobicity of 13 strains of Bifidobacterium longum. Lett. Appl. Microbiol. 2000, 31, 438–442. [Google Scholar] [CrossRef]
- dos Santos Leandro, E.; Ginani, V.C.; de Alencar, E.R.; Pereira, O.G.; Rose, E.C.P.; do Vale, H.M.M.; Pratesi, R.; Hecht, M.M.; Cavalcanti, M.H.; Tavares, C.S.O. Isolation, identification, and screening of lactic acid bacteria with probiotic potential in silage of different species of forage plants, cocoa beans, and artisanal salami. Probiotics Antimicrob. Proteins 2020, 13, 173–186. [Google Scholar] [CrossRef]
- Vinderola, C.G.; Reinheimer, J.A. Lactic acid starter and probiotic bacteria: A comparative “in vitro” study of probiotic characteristics and biological barrier resistance. Food Res. Int. 2003, 36, 895–904. [Google Scholar] [CrossRef]
- Missotten, J.; Goris, J.; Michiels, J.; Van Coillie, E.; Herman, L.; De Smet, S.; Dierick, N.; Heyndrickx, M. Screening of isolated lactic acid bacteria as potential beneficial strains for fermented liquid pig feed production. Anim. Feed Sci. Technol. 2009, 150, 122–138. [Google Scholar] [CrossRef]
- De Vries, M.C.; Vaughan, E.E.; Kleerebezem, M.; de Vos, W.M. Lactobacillus plantarum-survival, functional and potential probiotic properties in the human intestinal tract. Int. Dairy J. 2006, 16, 1018–1028. [Google Scholar] [CrossRef]
- Ozcan, T.; Yilmaz-Ersan, L.; Akpinar-Bayizit, A.; Delikanli, B. Antioxidant properties of probiotic fermented milk supplemented with chestnut flour (Castanea sativa Mill). J. Food Process. Preserv. 2017, 41, e13156. [Google Scholar] [CrossRef]
- Das, D.; Goyal, A. Antioxidant activity and γ-aminobutyric acid (GABA) producing ability of probiotic Lactobacillus plantarum DM5 isolated from Marcha of Sikkim. LWT-Food Sci. Technol. 2015, 61, 263–268. [Google Scholar] [CrossRef]
- Li, S.; Zhao, Y.; Zhang, L.; Zhang, X.; Huang, L.; Li, D.; Niu, C.; Yang, Z.; Wang, Q. Antioxidant activity of Lactobacillus plantarum strains isolated from traditional Chinese fermented foods. Food Chem. 2012, 135, 1914–1919. [Google Scholar] [CrossRef]
- Amaretti, A.; Di Nunzio, M.; Pompei, A.; Raimondi, S.; Rossi, M.; Bordoni, A. Antioxidant properties of potentially probiotic bacteria: In vitro and in vivo activities. Appl. Microbiol. Biotechnol. 2013, 97, 809–817. [Google Scholar] [CrossRef] [PubMed]
- Wang, Y.; Wu, Y.; Wang, Y.; Xu, H.; Mei, X.; Yu, D.; Wang, Y.; Li, W. Antioxidant properties of probiotic bacteria. Nutrients 2017, 9, 521. [Google Scholar] [CrossRef]
- Batista, V.L.; Da Silva, T.F.; De Jesus, L.C.L.; Dias Coelho-Rocha, N.; Barroso, F.A.L.; Tavares, L.M.; Azevedo, V.A.D.C.; Mancha-Agresti, P.D.C.; Drumond, M.M. Probiotics, prebiotics, synbiotics, and paraprobiotics as a therapeutic alternative for intestinal mucositis running head: Alternative treatment for intestinal mucositis. Front. Microbiol. 2020, 11, 544490. [Google Scholar] [CrossRef] [PubMed]
- De Castro-Cislaghi, F.P.; Carina Dos Reis, E.S.; Fritzen-Freire, C.B.; Lorenz, J.G.; Sant’Anna, E.S. Bifidobacterium Bb-12 microencapsulated by spray drying with whey: Survival under simulated gastrointestinal conditions, tolerance to NaCl, and viability during storage. J. Food Eng. 2012, 113, 186–193. [Google Scholar] [CrossRef]
- Markowiak, P.; Śliżewska, K. Effects of probiotics, prebiotics, and synbiotics on human health. Nutrients 2017, 9, 1021. [Google Scholar] [CrossRef] [PubMed]
- Reddy, K.B.P.K.; Madhu, A.N.; Prapulla, S.G. Comparative survival and evaluation of functional probiotic properties of spray-dried lactic acid bacteria. Int. J. Dairy Technol. 2009, 62, 240–248. [Google Scholar] [CrossRef]
- Santivarangkna, C.; Higl, B.; Foerst, P. Protection mechanisms of sugars during different stages of preparation process of dried lactic acid starter cultures. Food Microbiol. 2008, 25, 429–441. [Google Scholar] [CrossRef]

| Isolates | Viable Cell (logCFU/mL) | Survival Rate (%) | Viable Cell (logCFU/mL) | Survival Rate (%) | ||
|---|---|---|---|---|---|---|
| pH 7.2 | pH 2.0 | Without Bile | 0.3% Bile | |||
| A5-1 | 8.57 ± 0.12 | 6.89 ± 0.03 | 80.4 ± 0.4 i | 8.40 ± 0.05 | 4.15 ± 0.06 | 49.4 ± 0.5 h |
| A9-2 | 8.23 ± 0.01 | 7.82 ± 0.08 | 95.0 ± 0.6 a | 8.55 ± 0.07 | 7.85 ± 0.08 | 91.8 ± 1.4 a |
| A10-1 | 8.44 ± 0.04 | 6.95 ± 0.12 | 82.3 ± 1.7 hi | 8.23 ± 0.12 | 6.32 ± 0.04 | 76.8 ± 0.6 e |
| A13-5 | 8.24 ± 0.04 | 7.46 ± 0.10 | 90.5 ± 0.8 bcd | 8.45 ± 0.04 | 3.82 ± 0.07 | 45.2 ± 0.8 ij |
| A14-2 | 8.11 ± 0.12 | 6.71 ± 0.11 | 82.7 ± 0.9 ghi | 8.06 ± 0.07 | 3.87 ± 0.05 | 48.0 ± 1.3 hi |
| A14-6 | 8.68 ± 0.09 | 8.26 ± 0.07 | 95.2 ± 0.5 a | 8.52 ± 0.09 | 7.75 ± 0.21 | 91.0 ± 1.8 a |
| A21-4 | 8.67 ± 0.06 | 7.75 ± 0.02 | 89.4 ± 1.4 cde | 8.15 ± 0.16 | 5.28 ± 0.02 | 64.8 ± 0.9 g |
| A26-8 | 8.45 ± 0.17 | 7.84 ± 0.04 | 92.8 ± 0.3 ab | 8.66 ± 0.02 | 7.45 ± 0.06 | 86.0 ± 1.5 b |
| A27-3 | 8.16 ± 0.10 | 7.31 ± 0.06 | 89.6 ± 0.5 cde | 8.43 ± 0.12 | 6.61 ± 0.08 | 78.4 ± 1.6 de |
| A29-1 | 8.71 ± 0.12 | 7.33 ± 0.03 | 84.2 ± 0.7 gh | 8.89 ± 0.13 | 6.33 ± 0.05 | 71.2 ± 0.7 f |
| CMY1 | 8.10 ± 0.09 | 7.14 ± 0.04 | 88.1 ± 0.6 de | 8.77 ± 0.07 | 3.48 ± 0.17 | 39.7 ± 0.5 k |
| CMY9 | 8.14 ± 0.07 | 7.42 ± 0.09 | 91.2 ± 0.4 bc | 8.45 ± 0.13 | 7.15 ± 0.03 | 84.6 ± 1.1 bc |
| CMY12 | 8.27 ± 0.07 | 7.21 ± 0.15 | 87.2 ± 0.6 ef | 8.62 ± 0.04 | 3.75 ± 0.12 | 43.5 ± 0.9 j |
| CMY34 | 8.62 ± 0.15 | 7.36 ± 0.08 | 85.4 ± 1.2 fg | 8.28 ± 0.04 | 3.46 ± 0.05 | 41.8 ± 1.6 jk |
| CMY46 | 8.57 ± 0.02 | 7.85 ± 0.06 | 91.6 ± 1.5 cd | 8.41 ± 0.06 | 6.89 ± 0.07 | 81.9 ± 0.8 cd |
| CMY47 | 8.46 ± 0.08 | 7.58 ± 0.10 | 89.6 ± 0.6 de | 8.32 ± 0.08 | 6.52 ± 0.13 | 78.4 ± 1.9 de |
| Isolates | Closest Species | Similarity (%) | Length (bp) | Accession Number | Note |
|---|---|---|---|---|---|
| A9-2 | Lactobacillus plantarum ATCC 14917 | 99.8 | 1486 | MW564014 | recA gene confirmed |
| A14-6 | Lactobacillus pentosus DSM 20314 | 99.9 | 1467 | MW564015 | recA gene confirmed |
| A26-8 | Lactobacillus pentosus DSM 20314 | 99.9 | 1476 | MW564016 | recA gene confirmed |
| CMY9 | Pediococcus pentosaceus DSM 20336 | 99.9 | 1476 | MW564017 | - |
| CMY46 | Lactobacillus pentosus DSM 20314 | 99.5 | 1472 | MW564018 | recA gene confirmed |
| Isolates | Antibiotics | ||||||
|---|---|---|---|---|---|---|---|
| VA | K | CN | S | TE | E | PB | |
| L. plantarum A9-2 | R | I | S | R | S | S | R |
| L. pentosus A14-6 | R | R | I | R | S | S | R |
| L. pentosus A26-8 | R | R | I | R | S | S | R |
| P. pentosaceus CMY9 | R | R | I | R | S | S | R |
| L. pentosus CMY46 | R | R | I | R | S | S | R |
| Isolates | Viable Cell (logCFU/g) | Survival Rate (%) | |
|---|---|---|---|
| Before Spray-Drying | After Spray-Drying | ||
| L. plantarum A9-2 | 8.42 ± 0.02 | 6.41 ± 0.07 | 76.1 ± 0.65 bc |
| L. pentosus A14-6 | 8.61 ± 0.06 | 6.58 ± 0.11 | 76.4 ± 0.74 bc |
| L. pentosus A26-8 | 8.49 ± 0.11 | 6.39 ± 0.05 | 75.3 ± 0.38 c |
| P. pentosaceus CMY9 | 8.55 ± 0.07 | 6.86 ± 0.04 | 80.2 ± 0.18 a |
| L. pentosus CMY46 | 8.36 ± 0.09 | 6.48 ± 0.05 | 77.5 ± 0.23 b |
Publisher’s Note: MDPI stays neutral with regard to jurisdictional claims in published maps and institutional affiliations. |
© 2021 by the authors. Licensee MDPI, Basel, Switzerland. This article is an open access article distributed under the terms and conditions of the Creative Commons Attribution (CC BY) license (https://creativecommons.org/licenses/by/4.0/).
Share and Cite
Unban, K.; Chaichana, W.; Baipong, S.; Abdullahi, A.D.; Kanpiengjai, A.; Shetty, K.; Khanongnuch, C. Probiotic and Antioxidant Properties of Lactic Acid Bacteria Isolated from Indigenous Fermented Tea Leaves (Miang) of North Thailand and Promising Application in Synbiotic Formulation. Fermentation 2021, 7, 195. https://doi.org/10.3390/fermentation7030195
Unban K, Chaichana W, Baipong S, Abdullahi AD, Kanpiengjai A, Shetty K, Khanongnuch C. Probiotic and Antioxidant Properties of Lactic Acid Bacteria Isolated from Indigenous Fermented Tea Leaves (Miang) of North Thailand and Promising Application in Synbiotic Formulation. Fermentation. 2021; 7(3):195. https://doi.org/10.3390/fermentation7030195
Chicago/Turabian StyleUnban, Kridsada, Wirunya Chaichana, Sasitorn Baipong, Aliyu Dantani Abdullahi, Apinun Kanpiengjai, Kalidas Shetty, and Chartchai Khanongnuch. 2021. "Probiotic and Antioxidant Properties of Lactic Acid Bacteria Isolated from Indigenous Fermented Tea Leaves (Miang) of North Thailand and Promising Application in Synbiotic Formulation" Fermentation 7, no. 3: 195. https://doi.org/10.3390/fermentation7030195
APA StyleUnban, K., Chaichana, W., Baipong, S., Abdullahi, A. D., Kanpiengjai, A., Shetty, K., & Khanongnuch, C. (2021). Probiotic and Antioxidant Properties of Lactic Acid Bacteria Isolated from Indigenous Fermented Tea Leaves (Miang) of North Thailand and Promising Application in Synbiotic Formulation. Fermentation, 7(3), 195. https://doi.org/10.3390/fermentation7030195

